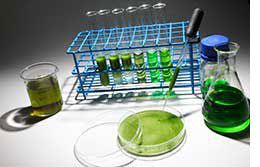

Удивительный морской критмум в антивозрастной косметике

Полукустарник критмум (морской укроп) можно найти среди камней и скал на берегу моря. Это растение семейства зонтичных. Критмум – не самое красивое растение, но вытяжка из него обладает целебными свойствами. Экстракт критмума обогащен минералами, морской солью и микроэлементами, поэтому он весьма полезен для нашего здоровья и красоты.
Из плодов, листьев и цветков этого растения добывается эфирное масло. Оно содержит калий, поэтому обладает свойством выводить лишнюю жидкость из тканей. Помимо этого, в нем можно найти магний, марганец, цинк, железо, комплекс витаминов и хлорогеновую кислоты, которая работает в качестве мощного антиоксиданта, к тому же защищает кожные покровы от негативного влияния ультрафиолетовых лучей. Вытяжка морского критмума минерализирует организм, выводит из него токсины, защищает клетки кожи от внешних разрушающих факторов, предотвращает чрезмерное накопление липидов и оказывает восстанавливающее действие. Все эти характеристики делают растение незаменимым помощником в деле сохранения красоты и здоровья кожных покровов лица и тела. Экстракт критмума отлично дренирует кожу и повышает ее тургор.
Стволовые клетки растений
В составе косметических антивозрастных препаратов нередко можно встретить растительные стволовые клетки, которые несут в себе генетическую информацию о процессах жизнедеятельности того или иного представителя флоры. Максимальное количество растительных стволовых клеток содержится в ростках, почках и молодых корнях. На протяжении всей жизни растения стволовые клетки сохраняют способность к делению и остаются активными.
Растительные стволовые клетки содержат:
- жирные и нуклеиновые кислоты
- витаминные комплексы
- фитогормоны
- ферменты пролиферации и антиоксидантной защиты
Способы получения растительных стволовых клеток
Самое большое количество стволовых клеток из растений позволяет добыть биотехнологический метод. Он заключается в следующем. Участок ткани растения намеренно повреждается, из него получают каллус (клеточную массу). Затем биологическая масса наращивается путем помещения каллуса в жидкую среду. Далее следует гомогенизация продукта, после чего из него выделяют нужные активные ингредиенты. К сожалению, эта методика имеет свои недостатки – полученные таким путем клетки по своим характеристикам несколько отличаются от подлинных мерисистемных клеток, так как в процессе работы они в некоторой степени теряют способность к регенерации.
Самое большое количество стволовых клеток из растений позволяет добыть биотехнологический метод. Он заключается в следующем. Участок ткани растения намеренно повреждается, из него получают каллус (клеточную массу). Затем биологическая масса наращивается путем помещения каллуса в жидкую среду. Далее следует гомогенизация продукта, после чего из него выделяют нужные активные ингредиенты. К сожалению, эта методика имеет свои недостатки – полученные таким путем клетки по своим характеристикам несколько отличаются от подлинных мерисистемных клеток, так как в процессе работы они в некоторой степени теряют способность к регенерации.
Есть и второй способ, с помощью которого можно добыть растительные стволовые клетки. Здесь используются почки, побеги и молодые корни. В начале весны флору собирают, обрабатывают и выделяют нужные компоненты. Эта методика, хоть и позволяет получить значительно меньшее количество растительных стволовых клеток, чем при применении биотехнологического метода, но зато в результате остаются наиболее жизнеспособные и действенные компоненты.
Многолетние лабораторные исследования доказали, что многие вещества, которые регулируют рост и метаболические процессы, как у растений, так и у человека, часто выполняют сходные и даже одинаковые функции. Например, отдельные растительные гормоны влияют на обменные процессы в человеческом теле, кроме того, сами в нем образуются. В растительных стволовых клетках содержатся ферменты, которые эффективно нейтрализуют действие свободных радикалов и у растений, и у людей.
Использование растительных стволовых клеток в косметических средствах
Растительные стволовые клетки можно встретить в составах, как профессиональных косметических препаратах, так и в средствах для домашнего применения. Они являются активными биологическими стимуляторами деятельности клеток человеческого тела, поскольку в них присутствуют факторы роста, которые регулируют рост, деление и метаболические процессы. В процессе старения организма в нем происходит множество патологических процессов. И экстракты мерисистемных клеток способны их корректировать и замедлять.
 Французская компания Algologie уже многие годы занимает лидирующие позиции на мировом косметологическом рынке. Основной акцент сделан на разработку и производство талассокосметики. Это неудивительно, поскольку лаборатория находится на морском берегу бретонского полуострова Пен Лан, вблизи самой крупной европейской долины водорослей. Там обитает свыше шестисот видов морской флоры. Добытое сырье немедленно идет в производстве, что <>обеспечивает полную натуральность продукции, которая имеет уважаемый европейский сертификат Ecocert– свидетельство высокой эффективности и экологичности выпускаемых препаратов.
Французская компания Algologie уже многие годы занимает лидирующие позиции на мировом косметологическом рынке. Основной акцент сделан на разработку и производство талассокосметики. Это неудивительно, поскольку лаборатория находится на морском берегу бретонского полуострова Пен Лан, вблизи самой крупной европейской долины водорослей. Там обитает свыше шестисот видов морской флоры. Добытое сырье немедленно идет в производстве, что <>обеспечивает полную натуральность продукции, которая имеет уважаемый европейский сертификат Ecocert– свидетельство высокой эффективности и экологичности выпускаемых препаратов.
В антивозрастной линии марки Algologie активно используется экстракт морского критмума. Растительные факторы роста способствуют делению клеток базального слоя эпидермиса и выработке фибробластами коллагена и эластина, а также синтезу гликозаминогликанов. Стволовые клетки критмума обеспечивают работу восстановительных функций кожных покровов, а также борются с активностью свободных радикалов.
Антивозрастные препараты Algologie с экстрактом морского критмума
 Набор для профессиональной процедуры BLUE LINE «Лифтинг и Сияние». Продукты для коррекции возрастных изменений, повышения тургора и тонуса, для избавления кожи от стресса, осветления пигментных пятен. Рекомендован для любого типа кожи. Применяется после сорока лет. Растительные стволовые клетки выращены в стерильных условиях биореактора с сохранением всех целебных для кожи свойств. В составе набора пилинг двойного действия «Сияние», маска для лица на базе измельченных водорослей, антипигментная сыворотка для лица с эффектом лифтинга, укрепляющая альгинатная маска с витамином С.
Набор для профессиональной процедуры BLUE LINE «Лифтинг и Сияние». Продукты для коррекции возрастных изменений, повышения тургора и тонуса, для избавления кожи от стресса, осветления пигментных пятен. Рекомендован для любого типа кожи. Применяется после сорока лет. Растительные стволовые клетки выращены в стерильных условиях биореактора с сохранением всех целебных для кожи свойств. В составе набора пилинг двойного действия «Сияние», маска для лица на базе измельченных водорослей, антипигментная сыворотка для лица с эффектом лифтинга, укрепляющая альгинатная маска с витамином С.
Дневной крем для лица "Начало молодости" (Артикул: 24120N). Продукт рекомендован к использованию при любом типе кожи при первоначальных следах увядания. Глубоко гидратирует кожу, восстанавливает ее цвет и придает здоровое сияние. Предотвращает появление морщин.
Сыворотка для лица ультра – регенерирующая (Артикул: 231220). Этот активный препарат используется для всех типов кожи после 30 лет. Возвращает кожным покровам должный тургор, нейтрализует действие свободных радикалов, осветляет пигментные пятна, дарит лицу здоровый и яркий цвет, улучшает текстуру кожи.
Маска для лица клеточная питательная (Артикул: 231120).Средство «мгновенной красоты» для возрастной группы 50+. Мгновенно подтягивает кожу, делает ее гладкой и яркой, оказывая быстрый визуальный эффект. Осветляет пигментные пятна, выравнивает текстуру кожи.
Крем для лица омолаживающий (Артикул: 24111N). Продукт интенсивного действия предназначен для профилактики и коррекции возрастных изменений. Подходит для любого типа кожи. Оказывает стойкий подтягивающий эффект. Минимизирует морщины, дарит коже сияние и ощущение комфорта, осветляет пигментные пятна, смягчает кожу, выводит из тканей излишнюю жидкость.
Сыворотка для лица и шеи корректирующая (Артикул: 231140). Средство «мгновенной красоты». Оказывает выраженное лифтинговое действие. Подходит для всех типов кожи с возрастными изменениями. Моделирует овал лица, обладает миорелаксирующим действием. Предназначена для возрастной группы 40+.
Получить исчерпывающие ответы на все вопросы, касающиеся механизмов действия препаратов марки Algologie, и сделать заказ профессионалы сферы красивого бизнеса могут на обучающих семинарах, проводимых компании Смарт Бай.
Брошюры:
 |  |  |




